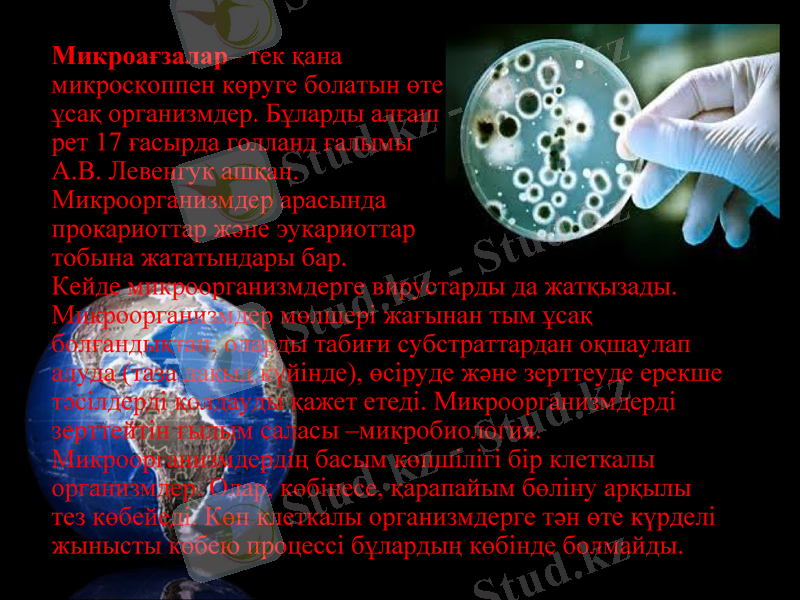
Slide 3

Микроорганизмдердің таралуы мен экологиялық және биогеохимиялық рөлі

Микроағзалар- тек қана микроскоппен көруге болатын өте ұсақ организмдер. Бұларды алғаш рет 17 ғасырда голланд ғалымы А. В. Левенгук ашқан. Микроорганизмдер арасында прокариоттар және эукариоттар тобына жататындары бар. Кейде микроорганизмдерге вирустарды да жатқызады. Микроорганизмдер мөлшері жағынан тым ұсақ болғандықтан, оларды табиғи субстраттардан оқшаулап алуда (таза дақыл күйінде), өсіруде және зерттеуде ерекше тәсілдерді қолдауды қажет етеді. Микроорганизмдерді зерттейтін ғылым саласы -микробиология. Микроорганизмдердің басым көпшілігі бір клеткалы организмдер. Олар, көбінесе, қарапайым бөліну арқылы тез көбейеді. Көп клеткалы организмдерге тән өте күрделі жынысты көбею процессі бұлардың көбінде болмайды.

Топырақта микроорганизмдерге кажетті қоректік заттар мол болады да, тікелей түскен күн сәулесінен оларды қорғап тұрады. Микроорганизмдердің топырақта таралуына табиғаттың толып жаткан жағдайлары әсер етеді. Бұлардың ішінде қоректік заттар, орта температурасы мен реакциясының маңызы зор. Топырақ микроорганизмдері күшті әрекет ететін ферменттер түзеді. Осындай ферменттердің көмегімен топырақтағы органикалық заттар ыдырап, өсімдіктерге оңай сіңетін қоректік заттарға айналады. Оны өсімдіктермен қатар, микроорганизмдер де қоректік зат есебінде пайдаланады. Топырақтағы микроорганизмдердің бір бөлігі өсіп-дамып көбейетін болса, екінші бөлігінің тіршілік процестері аяқталып, өлексеге айналады. Ондай өлекселермен тірі микробтар қоректеніп, ыдыратады. Ыдырау өнімінің қалдықтарынан қарашірік түзіледі.

Топырақтың төменгі қабаттарында су және ауа режимдерінің нашарлығынан оның органикалық қосылыстарға кедейлігіне байланысты микроорганизмдер ол қабаттарда аз болады. Сонымен қатар топырақ микроорганизмдерінің басым көпшілігі аэробты оргашзмдер. Топырақтағы микроорганизмдердің саны жыл маусымына байланысты өзгеріп отырады. Қыста азайып кетсе, жазда қайтадан көбейеді. Көптеген ғалымдар қыс кезінде топыракта тіршілік тежеледі, тіпті тоқтап қалады деген пікір айтып жүр. Ал Н. А. Красильниковтың байқауынша, қалың қар астындағы топырақ тоңға айналмай, ондағы микробиологиялык процестер үздіксіз жүріп жатады. Қыс кезінде басқа жыл маусымына қарағанда топырақта актиномицеттердің жақсы дамитыны анықталған. Микрооргаиизмдер тіршілігіне тапырақта болатын түрлі витамин, ауксин және басқа заттардың зор маңызы бар. Бұл заттардың азғана мөлшерінің өзі микроорганизмдердің тіршілігін қуаттайды. Соның нәтижесінде өсімдіктер де жақсы өсіп дамиды. Топыракты сақтау кезінде ондағы микробтар саны да бірнеше есе азаяды. Мұның өзі негізінен онда ылғалдық азаюымен байланысты.

Табиғатта кездесетін сулар - бактериялар мен саңырауқұлақтардың көп тараған екінші бір тіршілік ортасы болып есептеледі. Суға әрқашан күн сәулесі әсер еткенмен микроорганизмдердің өніп-өсуі үшін аса қауіпті емес. Микроорганизмдер қалыпты тіршілік етуі үшін, суда қажетті қоректік заттар жеткілікті мөлшерде болу керек. Суда органикалық заттар неғұрлым көп болса, бактериялар да соғүрлым көп кездеседі

Микроорганизмдер теңіз бен мұхит суларында, әсіресе олардың жағалауларында көп кездеседі. Жағадан қашықтаған сайын олардың саны азая береді. Шамамен 1 мл суда 1000 бактерия бар деп есептегенде бір шаршы километр суда бір тоннадай бактерия кездеседі. Олар судағы басқа тірі организмдерге әсерін тигізбей қоймайды.

Микроорганизмдер ауадағы молекуларық азотты сіңіруге де белсене қатысады. Ауа құрамында көбінесе вирус микроағзаның споралары жиі кездеседі. Әсіресе ауада түс беретін пигментті микроағзалар көбірек. Адамда көп жиналатын ауада микроағзалар саны әртүрлі болады. Сол себептен де терезені ашып үнемі бөлмені желдетіп отыру керек. Ірі өндіріс орталықтары орналасқан қалалардың ауасында микроағзалар саны мен сапасы әртүрлі болады. Жер бетінен биіктеген сайын микроағзалар саны азая түседі. Орманның ауасы таза болады.

Биогенді элементтердің айналымында - органикалық қалдықтарды минерализациялайтын деструктор микроорганизмдердің, тірі және өлі табиғат арасындағы микроб-делдалдардың рөлі орасан зор.
Санитар - микробтар планетаны токсиндік заттардан-аммиак, көмірсутек, метан, көмірқышқыл газ-угарный газ, шығу тегі антропогендік токсиндік заттар- ксенобиотиктер.
Геохимиялық рөлі - мұнай, көмір, металл және руда кендердің түзілуіне қатысады.
Микроорганизмдер суқоймаларының өнімділігіне, топырақтың түзілуіне және оның гумуспен байып құнарлануына септігін тигізеді

1. М. Х. Шығаева, Ә. Т. Қанаев «Микробиология және вирусология». Алматы, «Қазақуниверситеті» баспасы, 2008ж.
2. kk. wikipedia. org/wiki/
3. Лекциялар жинағы (презентация)
- Іс жүргізу
- Автоматтандыру, Техника
- Алғашқы әскери дайындық
- Астрономия
- Ауыл шаруашылығы
- Банк ісі
- Бизнесті бағалау
- Биология
- Бухгалтерлік іс
- Валеология
- Ветеринария
- География
- Геология, Геофизика, Геодезия
- Дін
- Ет, сүт, шарап өнімдері
- Жалпы тарих
- Жер кадастрі, Жылжымайтын мүлік
- Журналистика
- Информатика
- Кеден ісі
- Маркетинг
- Математика, Геометрия
- Медицина
- Мемлекеттік басқару
- Менеджмент
- Мұнай, Газ
- Мұрағат ісі
- Мәдениеттану
- ОБЖ (Основы безопасности жизнедеятельности)
- Педагогика
- Полиграфия
- Психология
- Салық
- Саясаттану
- Сақтандыру
- Сертификаттау, стандарттау
- Социология, Демография
- Спорт
- Статистика
- Тілтану, Филология
- Тарихи тұлғалар
- Тау-кен ісі
- Транспорт
- Туризм
- Физика
- Философия
- Халықаралық қатынастар
- Химия
- Экология, Қоршаған ортаны қорғау
- Экономика
- Экономикалық география
- Электротехника
- Қазақстан тарихы
- Қаржы
- Құрылыс
- Құқық, Криминалистика
- Әдебиет
- Өнер, музыка
- Өнеркәсіп, Өндіріс
Қазақ тілінде жазылған рефераттар, курстық жұмыстар, дипломдық жұмыстар бойынша біздің қор #1 болып табылады.



Ақпарат
Қосымша
Email: info@stud.kz